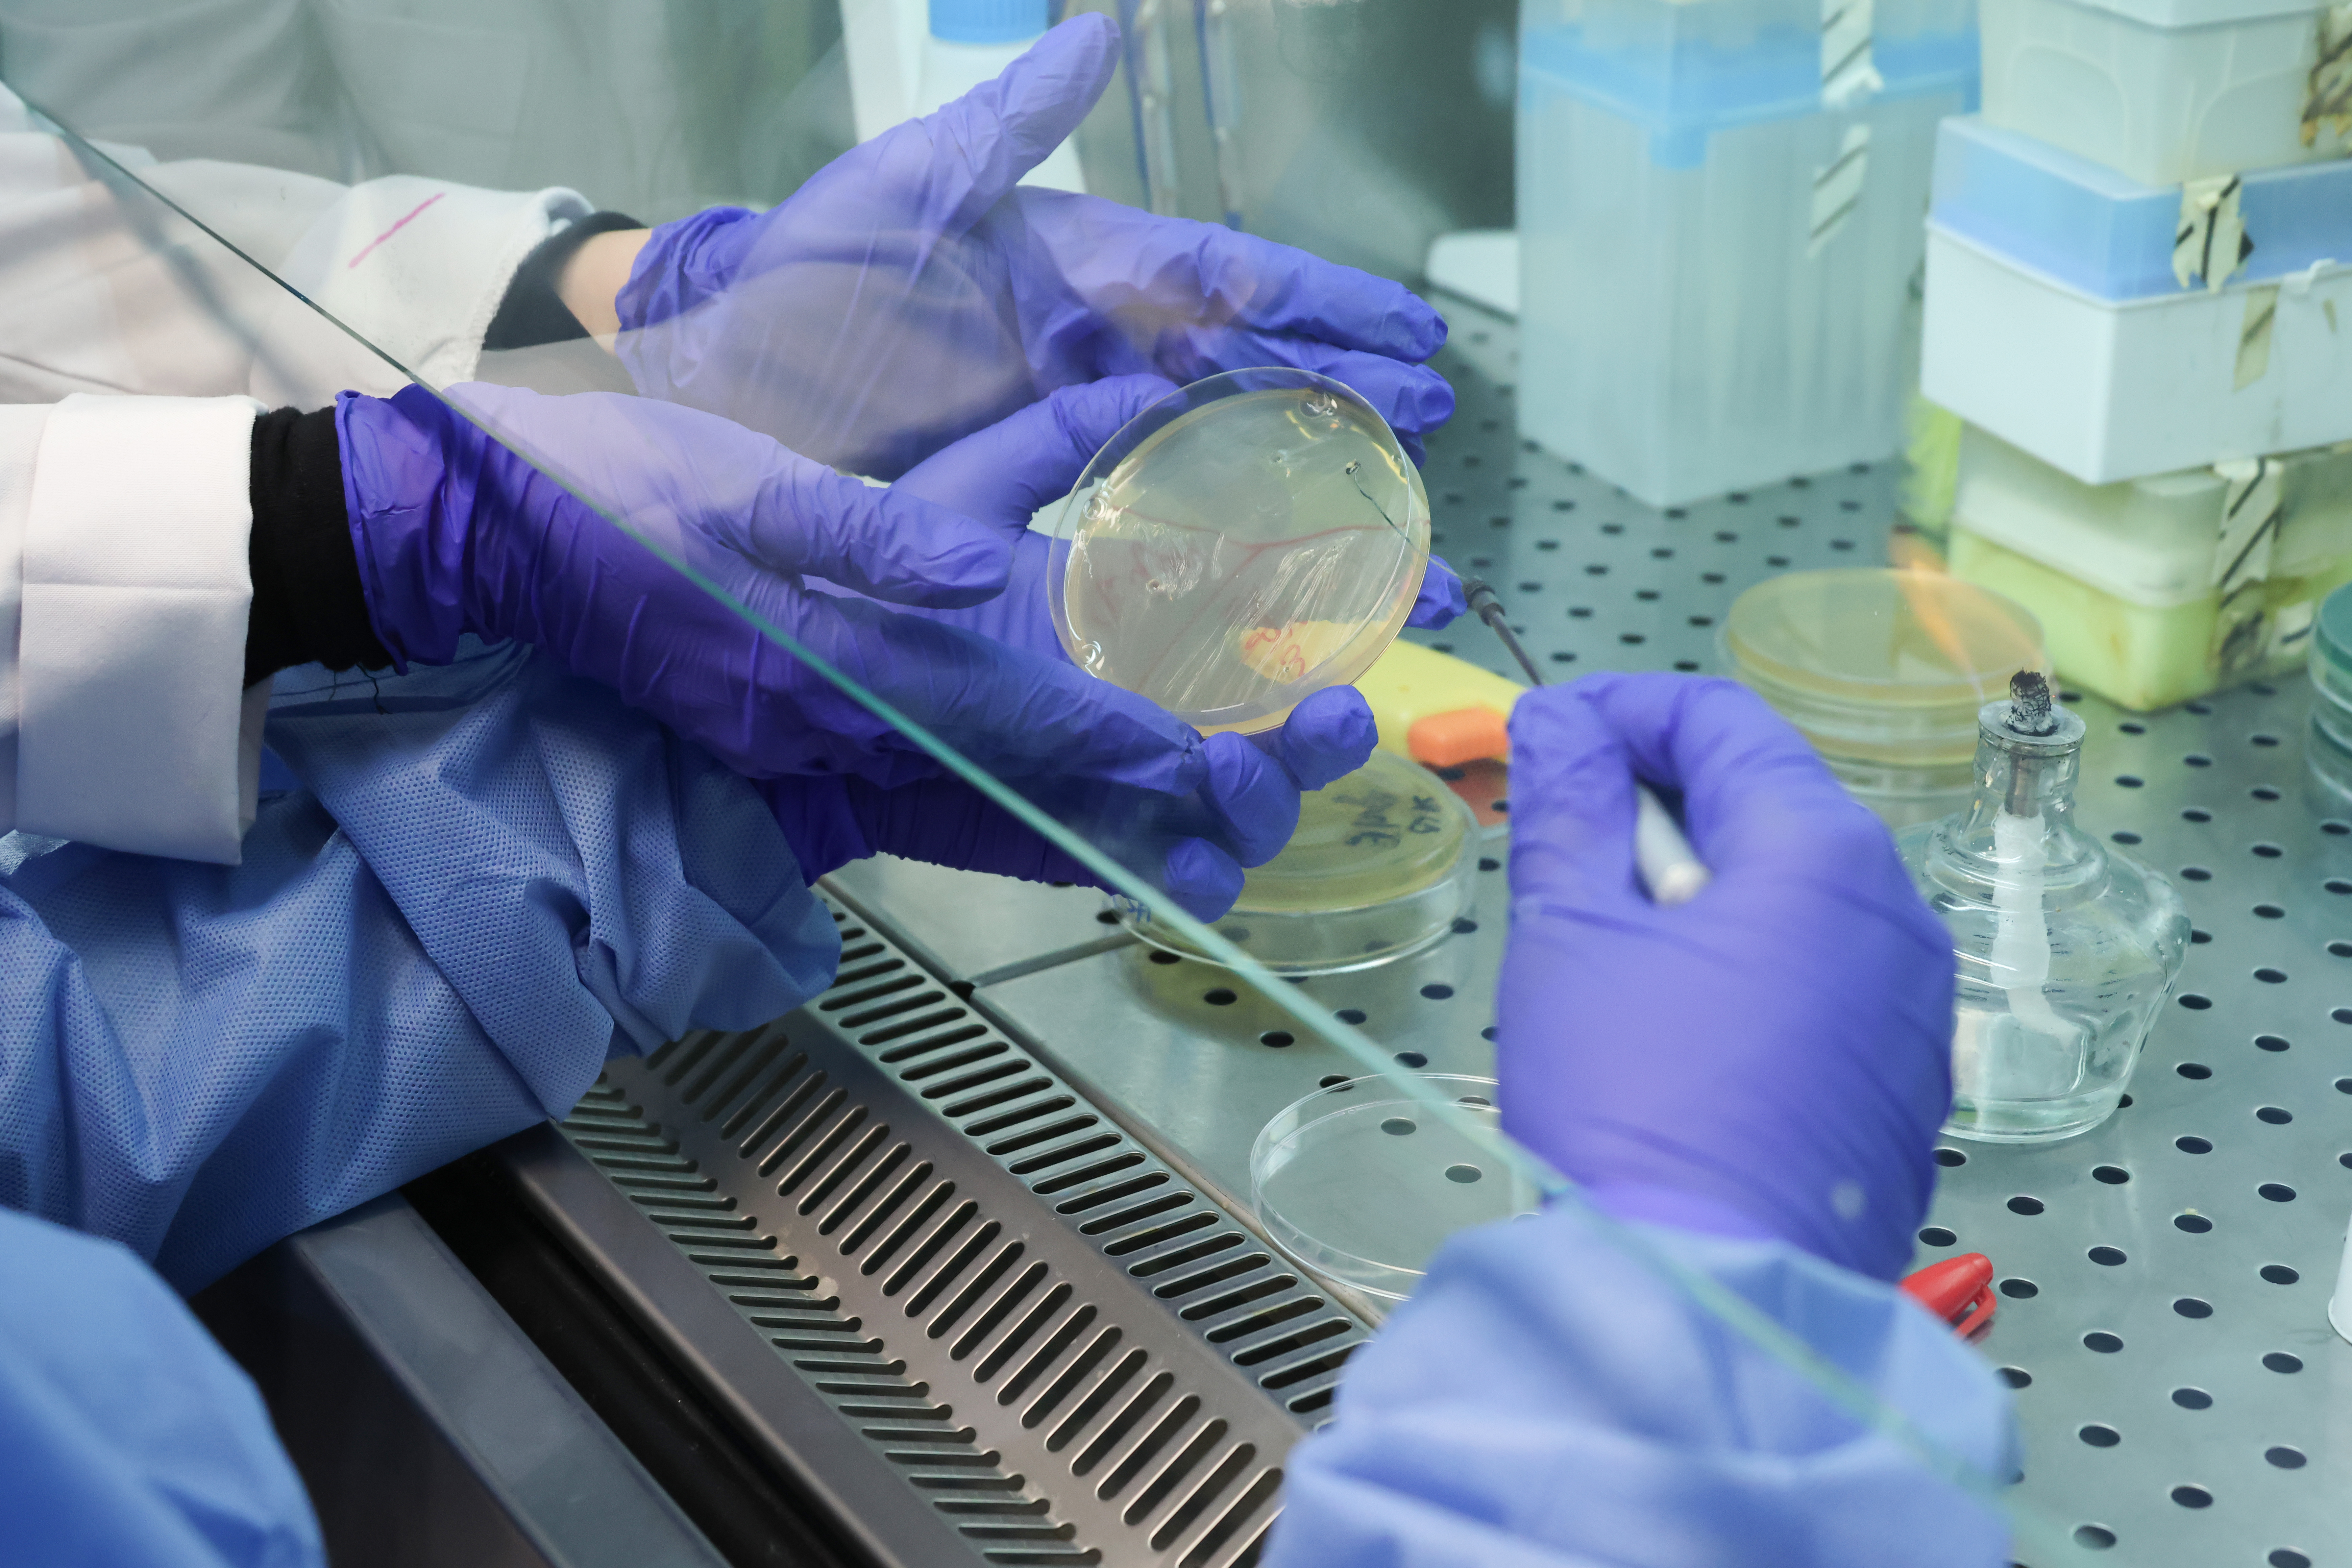

- Գլխավոր
- Նորություններ
- Գիտություն, փորձ և նոր մտածողություն․ աշխատաժողով դպրոցականների համար
Ապրիլ 27, 2026 | 15:00
Գիտություն
Կրթություն
Միջազգային համագործակցություն
Գիտություն, փորձ և նոր մտածողություն․ աշխատաժողով դպրոցականների համար
ԵՊՀ կենսաբանության ֆակուլտետում մեկնարկեց դպրոցականների համար նախատեսված գիտակրթական եռօրյա աշխատաժողովը, որը միավորում է միջազգային հեղինակավոր կազմակերպության փորձն ու համալսարանի գիտական ներուժը։ «Մանրէաբանությունը՝ առանց սահմանների․ «ASM» աշխատաժողով՝ ի պատիվ կ.գ.դ., պրոֆեսոր Արմեն Թռչունյանի» գիտական միջոցառումը նպատակ ունի ավագ դասարանների աշակերտներին ծանոթացնելու մանրէաբանության արդի միտումներին, դրա կիրառական նշանակությանը և գլոբալ մարտահրավերների լուծման մեջ ունեցած դերին՝ համադրելով տեսական դասախոսություններն ու գործնական լաբորատոր աշխատանքները։
Մանրէաբանությունը՝ առանց սահմանների
ԵՊՀ կենսաբանության ֆակուլտետի կենսաքիմիայի, մանրէաբանության և կենսատեխնոլոգիայի ամբիոնի ու «American Society for Microbiology»-ի (ASM) համատեղ նախաձեռնությամբ համալսարանում մեկնարկել է «Մանրէաբանությունը՝ առանց սահմանների․ «ASM» աշխատաժողով՝ ի պատիվ պրոֆեսոր Արմեն Թռչունյանի» խորագրով եռօրյա աշխատաժողովը։
Միջոցառումը նվիրված է անվանի գիտնական, պրոֆեսոր Արմեն Թռչունյանի 70-ամյակին։ Նրա գիտական գործունեությունն ու տարիների համագործակցությունը «ASM»-ի հետ հիմք են դարձել աշխատաժողովին հոբելյանական բնույթ հաղորդելու համար՝ միաժամանակ ընդգծելով նրա գիտական ժառանգության շարունակականությունը։
Աշխատաժողովի առանցքում ավագ դասարանների աշակերտներն են, որոնց համար ստեղծվել է միջավայր՝ ծանոթանալու մանրէաբանության արդի ուղղություններին և դրա կիրառական նշանակությանը։ Մասնակիցները հնարավորություն են ստանում ոչ միայն լսելու ոլորտի մասնագետների դասախոսությունները, այլև անմիջականորեն ներգրավվելու լաբորատոր աշխատանքներում՝ ձեռք բերելով գործնական հմտություններ և գիտական մտածողություն։
Ինչպես նշում է Հայաստանում «ASM» դեսպան, Կենսաքիմիայի, մանրէաբանության և կենսատեխնոլոգիայի ամբիոնի վարիչ Աննա Փոլադյանը, նախաձեռնությունն արդեն մի քանի տարի իրականացվում է՝ դառնալով սպասված և պահանջված հարթակ դպրոցականների համար։
«Եթե նախորդ տարիներին այն կազմակերպվում էր Մանրէների միջազգային օրվա շրջանակում, ապա այս տարի աշխատաժողովը առանձնանում է իր հոբելյանական թեմատիկ նշանակությամբ»,- նշեց Աննա Փոլադյանը:
Մանրէաբանությունը՝ գլոբալ խնդիրների լուծման առանցքում
Աշխատաժողովի ընթացքում ներկայացվում են մանրէաբանության արդի մարտահրավերներն ու դրանց լուծման հնարավորությունները՝ ընդգծելով ոլորտի առանցքային դերը ժամանակակից աշխարհում։ Քննարկվում են հակաբիոտիկների նկատմամբ կայունության աճը, շրջակա միջավայրի աղտոտման խնդիրները, հատկապես պլաստիկի և նանոպլաստիկի տարածվածությունը, ինչպես նաև մանրէների կիրառությունը կենսաբանական մաքրման և այլընտրանքային էներգիայի ստացման գործընթացներում։
Մասնակիցներին ներկայացվում է, թե ինչպես կարող են մանրէները ծառայել ոչ միայն որպես հետազոտության օբյեկտ, այլև որպես գործիք՝ լուծելու համաշխարհային նշանակության խնդիրներ՝ սկսած թափոնների վերամշակումից մինչև կենսաքայքայվող նյութերի ստեղծում։
Գիտական միջոցառման ձևաչափի մասին
Աննա Փոլադյանի խոսքով՝ ծրագրի առանձնահատկություններից է կրթության ինտերակտիվ ձևաչափը, ինչը խթանում է աշակերտների ակտիվ ներգրավվածությունն ու ստեղծարար մտածողությունը։
«Բացի դասախոսություններից՝ կանցկացվի նաև պանելային քննարկում, որտեղ աշակերտները հնարավորություն կունենան ուղղելու իրենց հարցերը և մասնակցելու մասնագիտական քննարկումների»,- հավելեց Աննա Փոլադյանը։
Աշխատաժողովի շրջանակում կիրառվում են նորարարական մեթոդներ, այդ թվում՝ լեգո-մոդելավորման միջոցով գաղափարների ներկայացում, ինչը նպաստում է ինչպես ստեղծագործական մտածողության, այնպես էլ թիմային աշխատանքի զարգացմանը։ Այս ձևաչափը կրթական գործընթացը դարձնում է առավել ներգրավող և հիշվող։
Աշխատաժողովի աշխարհագրական և թեմատիկ ընդգրկումը
Միջոցառումը մեծ արձագանք է ստացել դպրոցականների շրջանում․ գրանցվել է նախատեսվածից ավելի մեծ թվով մասնակցություն, ինչը վկայում է ծրագրի նկատմամբ հետաքրքրության աճի մասին։ Մասնակիցների թվում են ինչպես Երևանի, այնպես էլ ՀՀ մարզերի դպրոցների աշակերտներ, իսկ ոմանք մասնակցում են արդեն երկրորդ անգամ։
ԵՊՀ ՍԹԵՄ ավագ դպրոցի 10-րդ դասարանի աշակերտ Անդրանիկ Մելիքյանի խոսքով՝ թեև նախկինում հետաքրքրված էր կենսաբանությամբ, աշխատաժողովը հնարավորություն է տվել առավել խորությամբ հասկանալու ոլորտը, բացահայտելու նոր թեմաներ և ընդլայնելու պատկերացումները մանրէաբանության վերաբերյալ։
Նույն դպրոցի աշակերտ Արման Բարեղամյանը մատնանշեց, որ արդեն որոշ գիտելիքներ ուներ բակտերիաների և վիրուսների մասին, սակայն այստեղ ստացած տեղեկությունը զգալիորեն համալրել է իր գիտելիքների պաշարը։ Նրա համար հատկապես հետաքրքիր է եղել այն հանգամանքը, թե ինչպես են մանրէները ժամանակի ընթացքում հարմարվում նոր պայմաններին, ինչը կարևորում է գիտության շարունակական զարգացումը։
Երևանի Ջիվան Աբրահամյանի անվան №111 հիմնական դպրոցի 7-րդ դասարանի աշակերտ Գագիկ Հակոբյանը մեծ հետաքրքրությամբ է մասնակցել դասախոսություններին՝ առանձնացնելով հատկապես կաթնաթթվային բակտերիաների թեման և նշելով, որ ցանկալի է՝ նման նախաձեռնությունները լինեն շարունակական։
Նույն դպրոցի աշակերտ Էդգար Հարությունյանն ընդգծում է, որ թեև որոշ թեմաների ծանոթ էր, աշխատաժողովը հնարավորություն տվեց դրանք առավել խորությամբ ընկալելու։ Նրա խոսքով՝ հատկապես հետաքրքիր էր պլաստիկի վերամշակման և մանրէների միջոցով նոր նյութերի ստացման թեման։
Աշխատաժողովի ավարտին մասնակիցները կստանան հավաստագրեր՝ ամփոփելով ձեռք բերած գիտելիքներն ու փորձը։ Նախաձեռնությունը ևս մեկ կարևոր քայլ է դեպի գիտության հանրայնացում և երիտասարդների գիտական ներուժի բացահայտում՝ ԵՊՀ կրթական առաքելության շրջանակում։
Նշենք որ աշխատաժողովը շարունակվելու է մինչև ս․թ․ ապրիլի 29: